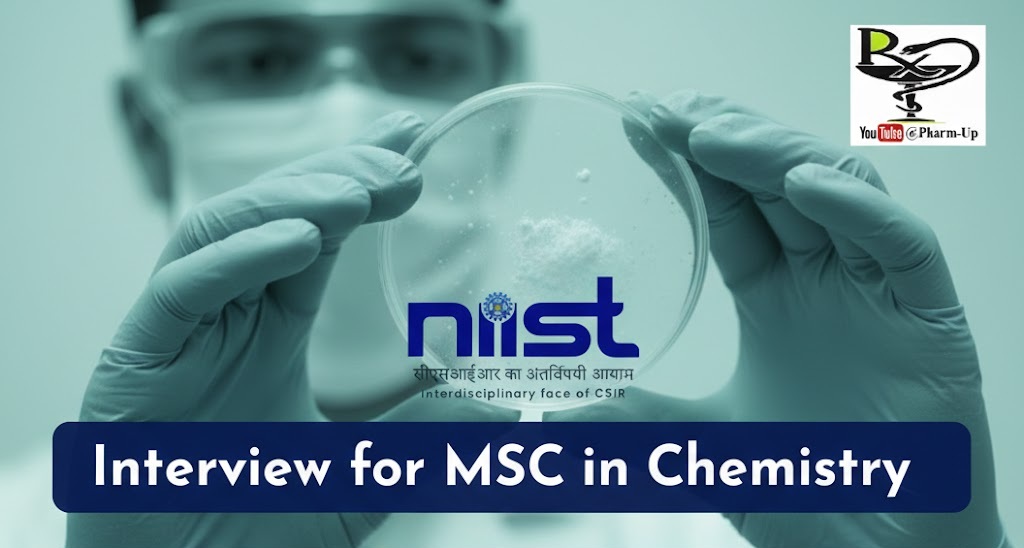

The National Institute for Interdisciplinary Science and Technology (NIIST), Thiruvananthapuram, a premier constituent laboratory of CSIR, is conducting a walk-in-interview for the position of Project Associate-I. This role is focused on the Materials Science and Technology Division (MSTD) and is purely temporary.
Position Details
| Feature | Details |
| Post Name | Project Associate-I |
| Post Code | MSTD-4 |
| Total Vacancies | 02 (plus a waitlist for future vacancies) |
| Monthly Stipend | ₹25,000 + 20% HRA |
| Max Age Limit | 35 Years (Relaxation for SC/ST/OBC/PwD/Females per GOI rules) |
Eligibility Criteria
- Educational Qualification: M.Sc. in Chemistry from a recognized University or equivalent.
- Result Status: Candidates must have their final results declared as of the date of the interview.
Selection Process & Reporting
- Mode: Walk-in-Interview (A written test may be conducted if the number of candidates is high).
- Reporting Time: 09:00 AM (Candidates arriving after 09:30 AM will not be allowed).
- Date of Interview: 03rd February 2026.
- Venue: CSIR-NIIST, Pappanamcode, Thiruvananthapuram.
How to Apply
- Download Form: Download the prescribed application form from the NIIST website.
- Fill & Sign: Complete the form and paste a recent passport-size photograph.
- Documentation: Prepare a set of self-attested photocopies of:
- Matriculation certificate (for age proof).
- Educational certificates and mark lists (from 10th grade onwards).
- Experience and Caste certificates (if applicable).
- Verification: You must bring all original certificates to the interview for physical verification.
Important Notes
- The position is co-terminus with the project duration.
- Waitlisted candidates will be valid for one year for any future vacancies in the department.
- No interim enquiries will be entertained.
